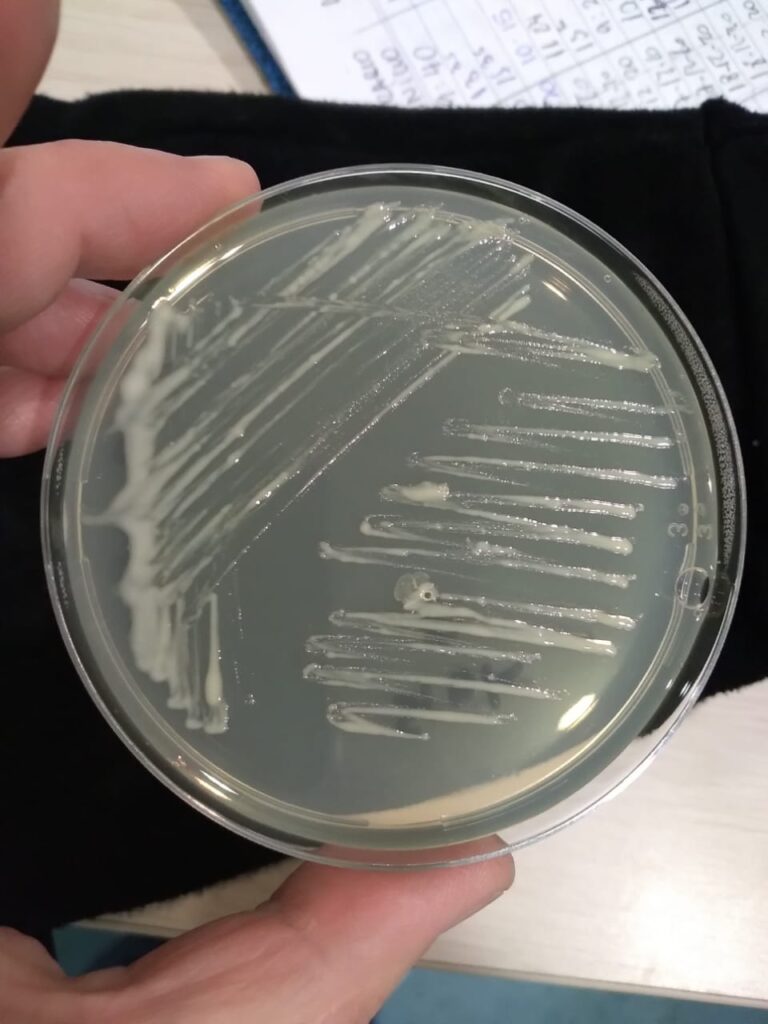

El Centro Interdisciplinario para la Investigación Acuícola y Hendrix Genetics, continúa estrechando su colaboración con la industria acuícola nacional y en esta oportunidad, se ha establecido una nueva alianza con el Laboratorio de Patología de Organismos Acuáticos y Biotecnología en Acuicultura de la Universidad Andrés Bello, dirigido por el investigador principal de la línea “Salud animal en estadios de vida de agua dulce de salmónidos”, Dr. Ruben Avendaño-Herrera, para profundizar en el estudio de la enfermedad bacteriana del riñón (BKD).
“El estudio permitirá confirmar y profundizar en el conocimiento de los mecanismos de virulencia de la bacteria, pero esta vez considerando la respuesta del hospedero, lo cual es muy relevante debido a que se trata de salmón Atlántico con un pedigrí genético conocido. Esta investigación posee un elemento radical el cual es contar con una métrica que define mucho más precisamente el fenotipo a medir y que permitirá apuntar mejor a la selección de las familias realmente resistentes y no simplemente sobrevivientes a la infección por BKD. Recordemos que por el carácter crónico de la enfermedad, las métricas usuales medidas en ensayos, no permiten dar cuenta con el objetivo del proyecto”, comenta el Dr. Avendaño-Herrera.
En el 2020, ambos grupos de investigación han sido pioneros en la generación de estudios transcriptómicos usando tejidos de salmón del Atlántico infectado experimentalmente con aislados chilenos de R. salmoninarum, siendo muy reveladores y sus resultados publicados en Rozas-Serri et al. (2020; doi: 10.3389/fimmu.2020.01378) y Eslamloo et al. (2020; doi: 10.3389/fimmu.2020.567838. eCollection 2020). Por tanto, se espera que esta colaboración entre Hendrix Genetics Aquaculture y la academia, genere conocimiento de excelencia, soluciones concretas y de rápida implementación.
“De hecho, la colaboración entre Hendrix Genetics e Incar permitirá acceder a familias de peces con características de resistencia, y buscar en esos ejemplares los biomarcadores genéticos más adecuados para el programa de selección genética para resistencia efectiva a BKD” detalla el Dr. Avendaño-Herrera.
Esta actividad se enlaza con la secuencia de investigaciones aplicadas por el equipo del Dr. Avendaño que comenzó el 2015 financiado por el proyecto FONDECYT Nº 1150695 y que han mostrado significativos avances, con exploración a nivel familiar de la empresa que le ha permitido definir cambios radicales al caracterizar el fenotipo adecuado a seleccionar. Entonces, mediante herramientas transcriptómicas se apoyará la estrategia de selección genética de familias más resistentes de salmón del Atlántico.
Imagen destacada:
Cultivo de R. salmoninarum crecida en placa de agar KDM-2.
(Dr. Ruben Avendaño-Herrera ©)